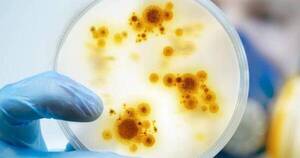

- Inicio
- jynneos
Etiquetas relacionadas

El Gobierno de Estados Unidos declaró este jueves la emergencia sanitaria nacional por el brote de viruela del mono que vive el país, en el que ya se han registrado miles de contagios aunque, de momento, ninguna muerte.
[Leer más]
Octubre 27, 2024

La Organización Mundial de la Salud (OMS) anunció este viernes que aprobó la primera vacuna específica contra la mpox (antes viruela del mono). La
[Leer más]
Septiembre 13, 2024

San Juan, 16 ago (EFE).- Las autoridades sanitarias de Puerto Rico aseguraron este viernes que los sistemas de vigilancia "están activos y en alerta" ante la evolución del mpox, antigua viruela del mono, la cual es más transmisible, severa y mortal.
[Leer más]
Agosto 16, 2024
Internacionales

La vacuna contra la viruela del mono es altamente efectiva y protege a las personas a las dos semanas después de la primera dosis, dijeron el miércoles los Centros para el Control y la Prevención de Enfermedades (CDC) de Estados Unidos. Un análisis p...
[Leer más]
Septiembre 30, 2022

La vacuna contra la viruela del mono es altamente efectiva y protege a las personas a las dos semanas después de la primera dosis, dijeron el miércoles los Centros para el Control y la Prevención de Enfermedades (CDC) de Estados Unidos. Un análisis p...
[Leer más]
Septiembre 30, 2022


La vacuna contra la viruela del mono es altamente efectiva y protege a las personas a las dos semanas después de la primera dosis, dijeron el miércoles los Centros para el Control y la Prevención de Enfermedades (CDC) de Estados Unidos.
[Leer más]
Septiembre 28, 2022
Internacionales

Las autoridades sanitarias de Estados Unidos anunciaron el jueves que llevarán a cabo ensayos clínicos para probar diferentes estrategias de dosificación de la vacuna contra la viruela del mono Jynneos, en medio de discusiones sobre su eficacia.
[Leer más]
Septiembre 08, 2022

Las autoridades sanitarias de Estados Unidos anunciaron este jueves que llevarán a cabo ensayos clínicos para probar diferentes estrategias de dosificación de la vacuna contra la viruela del mono Jynneos, en medio de discusiones sobre su eficacia.
[Leer más]
Septiembre 08, 2022
Internacionales

BRASILIA. La Agencia Nacional de Vigilancia Sanitaria de Brasil (Anvisa) liberó el uso de una vacuna y de un medicamento contra la viruela del mono, que ya deja en el país 4.144 infectados y un fallecido, informaron este viernes fuentes oficiales.
[Leer más]
Agosto 26, 2022
Internacionales

El laboratorio danés que produce la única vacuna autorizada contra la viruela del mono anunció el miércoles un acuerdo con la Organización Mundial de la Salud (OMS) para facilitar su distribución en América Latina y el Caribe.
[Leer más]
Agosto 24, 2022
Internacionales

COPENHAGUE. El laboratorio danés que produce la única vacuna autorizada contra la viruela del mono -detectada en 1958- anunció hoy un acuerdo con la Organización Mundial de la Salud (OMS) para facilitar su distribución en América Latina y el Caribe.
[Leer más]
Agosto 24, 2022
Internacionales

SAN JUAN. El Departamento de Salud de Puerto Rico anunció este sábado que los casos confirmados de viruela del mono en la isla ascienden a 50. Anunciaron que se unen a organizaciones de la comunidad LGBTTIQ para vacunar a los contactos de los contagiados.
[Leer más]
Agosto 13, 2022
Internacionales

Las autoridades estadounidenses autorizaron el martes un nuevo procedimiento de inyección de la vacuna contra la viruela del mono, que debe permitir vacunar más personas con la misma cantidad de producto, cuando escasean las dosis.
[Leer más]
Agosto 09, 2022
Internacionales

La salud forma parte del área de lo primordial no solo en la agenda de los gobiernos sino desde lo particular por lo que es importante contar con buena salud para trabajar, estudiar y emprender proyectos que son solo sustentables para poder trabaj...
[Leer más]
Agosto 05, 2022

La medida permitirá desembolsar más fondos para el sistema de salud y movilizar más personal.
[Leer más]
Agosto 05, 2022

Este jueves, el Gobierno de Estados Unidos declaró la emergencia sanitaria nacional por el brote de viruela del mono que vive el país, en el que ya se han
[Leer más]
Agosto 04, 2022

Con la confirmación de dos fallecimientos en España, uno en Brasil, uno en Perú y uno en la India, los especialistas analizan en qué casos la infección puede complicarse. Quiénes presentan mayor riesgo y quiénes deberían vacunarse. En tanto, en Paragua...
[Leer más]
Agosto 03, 2022
Nacionales

Los Centros de Control de Enfermedades (CDC) de Estados Unidos han determinado que la vacuna JYNNEOS, específica contra esta enfermedad, se ofrezca de manera prioritaria a todos los grupos de riesgo.
[Leer más]
Agosto 01, 2022
Internacionales

La ciudad de Nueva York declaró este sábado el estado de emergencia por ser uno de los "epicentros del brote" de la viruela del mono en Estados Unidos y estimó que "aproximadamente 150.000 neoyorquinos pueden estar actualmente en riesgo de exposición" ...
[Leer más]
Julio 31, 2022
Internacionales

Nueva York, 31 jul (EFE).- La ciudad de Nueva York declaró el sábado estado de emergencia por ser "el epicentro del brote" de la viruela del mono y estimó que "aproximadamente 150.000 neoyorquinos pueden estar actualmente en riesgo de exposición" de es...
[Leer más]
Julio 31, 2022
Internacionales

La ciudad de Nueva York declaró el sábado estado de emergencia por ser "el epicentro del brote" de la viruela del mono y estimó que "aproximadamente 150.000 neoyorquinos pueden estar actualmente en riesgo de exposición" de este virus.
[Leer más]
Julio 31, 2022
Internacionales

Tegucigalpa, 30 jul (EFE).- Honduras, que hasta ahora no ha detectado ningún contagio por la viruela del mono, anunció este sábado que gestiona la adquisición de 5.600 vacunas contra la enfermedad, luego de que la Organización Mundial de la Salud (OMS)...
[Leer más]
Julio 30, 2022
Internacionales

Washington, 29 jul (EFE).- El estado de Nueva York (EE.UU.) declaró este viernes el estado de emergencia por el aumento de casos de viruela del mono durante los últimos días, concentrado fundamentalmente en la ciudad de Nueva York.
[Leer más]
Julio 30, 2022
Internacionales

La Administración de Fármacos y Alimentos de EEUU (FDA, por sus siglas en inglés) aprobó este miércoles una autorización adicional para el uso en el país de las dosis de la vacuna contra la viruela y la viruela del mono fabricadas en una planta de la f...
[Leer más]
Julio 27, 2022
Internacionales

La Organización Mundial de la Salud (OMS) advirtió este martes que la vacuna por sí sola no pude detener la epidemia de viruela del mono y pidió que se adopten medidas para reducir el riesgo, «como limitar las parejas sexuales». «Pedimos, por el moment...
[Leer más]
Julio 26, 2022
Internacionales

La vacuna Imvanex ya estaba aprobada para prevenir la viruela. Ahora será el único fármaco autorizado para inmunizar también contra la viruela del mono.
[Leer más]
Julio 25, 2022
Internacionales

La Comisión Europea ha aprobado la extensión de una vacuna del grupo farmacéutico Bavarian Nordic contra la propagación de la viruela del mono, anunció este lunes el laboratorio danés.
[Leer más]
Julio 25, 2022
Internacionales

San Juan, 24 jul (EFE).- El Departamento de Salud (DS) de Puerto Rico reportó este domingo dos casos adicionales de viruela del mono en la isla, aumentando a 13 el total de contagiados por este virus en el territorio caribeño.
[Leer más]
Julio 24, 2022
Internacionales

San Juan, 18 jul (EFE).- El secretario del Departamento de Salud (DS), Carlos Mellado López, anunció este lunes el inicio del proceso de vacunación contra la viruela del mono en Puerto Rico, donde hay ocho casos confirmados y diez sospechosos.
[Leer más]
Julio 18, 2022
Internacionales

La Organización Mundial de la Salud (OMS) llamó este viernes a tomar medidas “urgentes” para contener la propagación de la viruela del mono en Europa, donde los casos se triplicaron en las últimas dos semanas. En un comunicado, el director regional de ...
[Leer más]
Julio 01, 2022
Internacionales

Las autoridades sanitarias de Estados Unidos extenderán la cobertura de vacunación contra la viruela del mono a la población que sospeche haber tenido contacto con una persona infectada, según trascendió este martes.
[Leer más]
Junio 29, 2022
Internacionales

Las autoridades sanitarias de Estados Unidos extenderán la cobertura de vacunación contra la viruela del mono a la población que sospeche haber tenido contacto con una persona infectada, según trascendió este martes. Para ello, los Centros para el Cont...
[Leer más]
Junio 29, 2022
Internacionales

LOS ÁNGELES. Las autoridades sanitarias de Estados Unidos extenderán la cobertura de vacunación contra la viruela del mono a todas las personas que sospechen haber tenido contacto con una persona infectada.
[Leer más]
Junio 29, 2022
Internacionales

Madrid, 28 jun (EFE).- España recibió este martes las primeras 5.300 dosis de la vacuna Jynneos contra viruela del mono, de las 110.000 adquiridas por toda la Unión Europea, informó el Ministerio de Sanidad, y anunció que se esperan "dos envíos más en ...
[Leer más]
Junio 28, 2022
Internacionales

Organización Mundial de la Salud estimará si es una “emergencia de salud pública internacional”.
[Leer más]
Junio 15, 2022

La vacuna fue la herramienta clave para lograr erradicar la viruela, pero ¿qué pasa ahora con la viruela del mono? Existe una vacuna específica para esta enfermedad, pero no hay una disponibilidad amplia a nivel mundial, y la vacuna contra la viruela q...
[Leer más]
Mayo 25, 2022

Estados Unidos planea distribuir vacunas de la viruela del mono y tratamientos médicos a los contactos cercanos de personas infectadas, ante los 5 casos sospechosos, teniendo en cuenta que esto podría ir aumentando.
[Leer más]
Mayo 24, 2022
Internacionales

Tras los 5 casos sospechosos de la viruela del mono, y teniendo en cuenta que esto podría ir aumentando, Estados Unidos planea distribuir vacunas contra la viruela y tratamientos médicos a los contactos cercanos de personas infectadas.
[Leer más]
Mayo 24, 2022
Internacionales

En términos de suministro, Estados Unidos tiene cerca de mil dosis del compuesto JYNNEOS, una vacuna aprobada por la Administración de Alimentos y Medicamentos de Estados Unidos (FDA) para la viruela común y la viruela del mono.
[Leer más]
Mayo 23, 2022
Internacionales
En términos de suministro, Estados Unidos tiene cerca de mil dosis del compuesto JYNNEOS, una vacuna aprobada por la Administración de Alimentos y Medicamentos de Estados Unidos (FDA) para la viruela común y la viruela del mono.
[Leer más]
Mayo 23, 2022
Internacionales

Estados Unidos planea distribuir vacunas de la viruela del mono y tratamientos médicos a los contactos cercanos de personas infectadas, cuando ya hay cinco casos confirmados o probables en ese país donde el brote parece aumentar, dijeron funcionarios e...
[Leer más]
Mayo 23, 2022
Internacionales